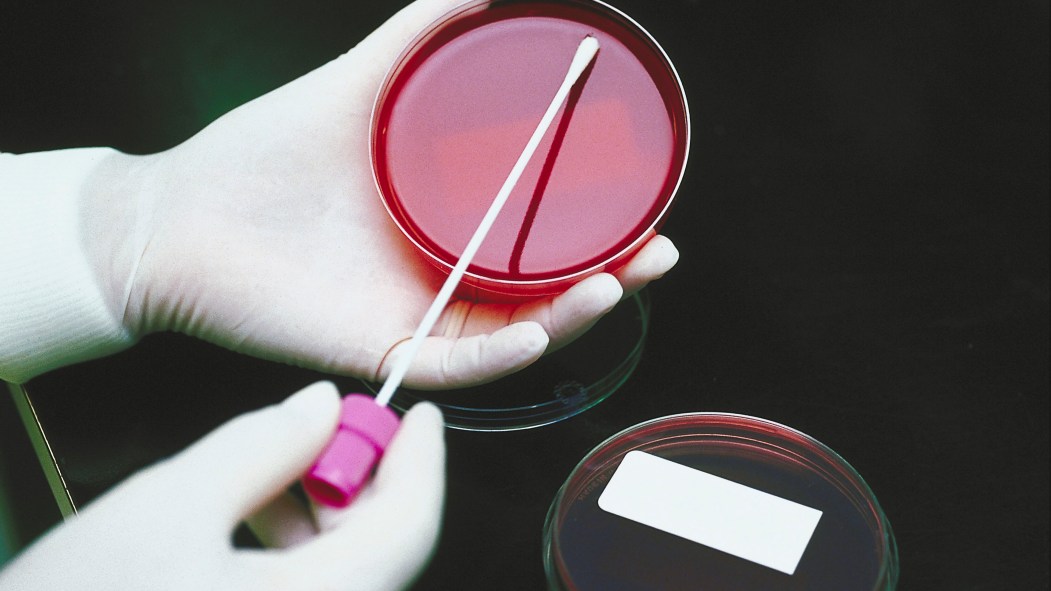

Les analyses biomédicales, essentielles pour permettre le diagnostic
Sang, urine, tissus, bactéries ou fluides : les prélèvements demandés par votre médecin sont analysés par un technologiste en analyses biomédicales. Au Québec, ils sont plus de 4 500 à effectuer des analyses et des examens dans le domaine de la biologie médicale.
Leurs tests de laboratoire, leurs expériences et leurs analyses permettent au médecin de diagnostiquer des maladies lorsque les symptômes apparents ne suffisent pas. Le rôle du technologiste médical est essentiel, puisque les résultats obtenus – et leur interprétation – orienteront la thérapie du patient.
Milieux de travail
Leurs services sont accessibles autant dans le secteur public que privé. Le milieu hospitalier, les CLSC, les centres de prélèvements, les centres de recherche et les institutions d’enseignement constituent leur terrain de jeu. On les retrouve également dans certaines industries (pharmaceutique, cosmétique, laitière et alimentaire), des cliniques vétérinaires et des laboratoires spécialisés en environnement et en biotechnologies.
Formation
D’une durée de trois ans, la formation d’études collégiales en Technologies d’analyses biomédicales est requise pour devenir technologiste médical. Le diplôme permet aussi d’exercer comme assistant en anatomopathologie, pour fournir une aide lors des autopsies et des examens de prélèvements ou pratiquer ces autopsies et ces examens sous la surveillance d’un pathologiste.
Pour porter le titre de technologiste médical, il faut aussi être membre de l’Ordre professionnel des technologistes médicaux du Québec (OPTMQ). Une dizaine de cégeps offrent le programme Technologie d’analyses biomédicales. Pour la liste complète, il suffit de consulter l’Inforoute de la formation professionnelle et technique au Québec.
Faits saillants
Le Québec comptait 6 000 technologistes médicaux en 2010.
- 51 % des technologistes ont entre 25 et 44 ans.
- Personnes diplômées : 231
- Proportion de femmes pour le programme : 81 %
- Diplômés en emploi : 89,4 %
- À temps plein : 92,3 %
- En rapport avec la formation : 98,5 %
- Taux de chômage : 0,7 %
- Durée de recherche d’emploi : 1 semaine
- Salaire annuel moyen : 49 920 $
- Perspectives d’emploi (2011-2015) : favorables
- Demande de main-d’œuvre (2011-2015) : élevée
Sources : La Relance au collégial en formation technique, MELS, 2011, Emploi-Québec et Tout pour réussir.



